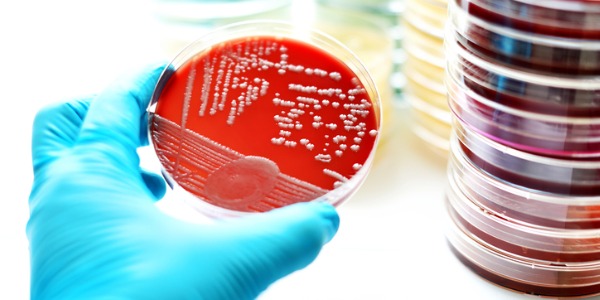
Bacteria culture in a petri dish.

What is an Infectious Disease Specialist?
An infectious disease specialist is a medical doctor who specializes in the prevention, diagnosis, and treatment of infectious diseases caused by bacteria, viruses, fungi, parasites, and other microorganisms. These specialists have expertise in managing a wide range of infectious conditions, including common infections like influenza, pneumonia, urinary tract infections, and skin infections, as well as more complex and rare diseases such as HIV/AIDS, tuberculosis, malaria, and Ebola.
Infectious disease specialists play an important role in public health by providing expert guidance on infection control measures, antibiotic stewardship, vaccination strategies, and outbreak management to prevent the spread of infectious diseases within communities and healthcare settings.
What does an Infectious Disease Specialist do?
Duties and Responsibilities
The duties and responsibilities of an infectious disease specialist encompass a wide range of tasks related to the prevention, diagnosis, treatment, and management of infectious diseases. Some of the key responsibilities of an infectious disease specialist include:
- Diagnosis of Infectious Diseases: Infectious disease specialists are responsible for diagnosing a variety of infectious conditions by evaluating patients' symptoms, medical histories, and laboratory test results. They use their expertise to identify the causative agents of infections, such as bacteria, viruses, fungi, or parasites, and determine the most appropriate diagnostic tests, including blood cultures, urine cultures, imaging studies, and molecular assays.
- Treatment Planning and Management: Based on the diagnosis, infectious disease specialists develop individualized treatment plans tailored to each patient's specific condition, medical history, and risk factors. They prescribe antimicrobial medications, such as antibiotics, antivirals, antifungals, or antiparasitic drugs, to eradicate or control the infectious agent. Infectious disease specialists also provide guidance on supportive care measures, infection control practices, and preventive strategies to optimize patient outcomes and minimize the risk of transmission.
- Antimicrobial Stewardship: Infectious disease specialists play a crucial role in promoting the appropriate use of antimicrobial medications and combating antimicrobial resistance. They oversee antimicrobial stewardship programs in healthcare facilities, which aim to optimize the selection, dosing, and duration of antimicrobial therapy, reduce unnecessary antibiotic use, and prevent the emergence of resistant pathogens. Infectious disease specialists collaborate with healthcare teams to implement evidence-based guidelines, conduct antimicrobial utilization reviews, and educate prescribers and patients about the importance of prudent antibiotic use.
- Infection Control and Prevention: Infectious disease specialists provide expert guidance on infection control measures to prevent the spread of infectious diseases within healthcare settings, communities, and populations. They develop infection control policies and protocols, conduct outbreak investigations, and implement strategies to minimize the risk of healthcare-associated infections, including hand hygiene practices, environmental cleaning, isolation precautions, and vaccination campaigns.
- Public Health Advocacy and Education: Infectious disease specialists advocate for public health initiatives and policies aimed at preventing and controlling infectious diseases on a local, national, and global scale. They engage in community outreach, public education campaigns, and health promotion activities to raise awareness about infectious diseases, promote vaccination uptake, and empower individuals to adopt preventive behaviors. Infectious disease specialists also contribute to infectious disease surveillance efforts, outbreak response efforts, and research endeavors to advance knowledge and improve public health outcomes related to infectious diseases.
Types of Infectious Disease Specialists
Infectious disease specialists can specialize in various areas within the field of infectious diseases, depending on their clinical interests, expertise, and practice settings. Some common types of infectious disease specialists include:
- HIV/AIDS Specialists (HIV Medicine Providers): These specialists focus specifically on the prevention, diagnosis, and management of HIV/AIDS and related complications. They provide comprehensive care to patients living with HIV/AIDS, including antiretroviral therapy (ART), management of opportunistic infections, monitoring of HIV viral load and CD4 cell count, and counseling on adherence to treatment and risk reduction behaviors. HIV/AIDS specialists may also offer pre- and post-exposure prophylaxis (PrEP and PEP) to prevent HIV transmission in high-risk individuals.
- Hospital-based Infectious Disease Specialists: These specialists work primarily in hospital settings, providing consultations and managing infectious diseases in hospitalized patients. They may oversee the care of patients with severe or complicated infections, such as sepsis, pneumonia, bloodstream infections, or surgical site infections. Hospital-based infectious disease specialists collaborate with other healthcare providers, including primary care physicians, surgeons, intensivists, and infection preventionists, to optimize patient care and outcomes.
- Infection Control Specialists: These specialists focus on preventing and controlling healthcare-associated infections (HAIs) in healthcare settings. They develop and implement infection control policies, protocols, and surveillance systems to reduce the risk of transmission of infectious diseases among patients, healthcare workers, and visitors. Infection control specialists conduct outbreak investigations, perform infection control audits and assessments, and provide education and training on infection prevention practices to healthcare staff.
- Outpatient Infectious Disease Specialists: These specialists focus on providing care to patients with infectious diseases in outpatient clinics or specialty practices. They evaluate and manage patients with a wide range of infectious conditions, including HIV/AIDS, sexually transmitted infections, tuberculosis, viral hepatitis, travel-related infections, and chronic infections requiring long-term antibiotic therapy. Outpatient infectious disease specialists may also offer preventive services, such as pre-travel consultations, immunizations, and pre-exposure prophylaxis (PrEP) for HIV prevention.
- Travel Medicine Specialists: These specialists focus on the prevention and management of infectious diseases associated with international travel and migration. They provide pre-travel consultations to assess travelers' health risks, administer recommended vaccinations and prophylactic medications, and offer advice on travel-related health precautions, such as food and water safety, insect bite prevention, and altitude sickness prevention. Travel medicine specialists may also evaluate and manage travelers returning from abroad with travel-related illnesses or infectious diseases acquired during their trips.
Infectious disease specialists have distinct personalities. Think you might match up? Take the free career test to find out if infectious disease specialist is one of your top career matches. Take the free test now Learn more about the career test
What is the workplace of an Infectious Disease Specialist like?
The workplace of an infectious disease specialist can vary depending on their specific area of expertise, practice setting, and patient population. However, infectious disease specialists typically work in diverse healthcare environments where they diagnose, treat, and manage infectious diseases. One common workplace for infectious disease specialists is hospitals, where they may serve as consultants or members of multidisciplinary teams caring for patients with complex or severe infections. In hospitals, infectious disease specialists may round on inpatients, provide consultations for infectious disease cases, and collaborate with other healthcare providers to develop and implement treatment plans.
Additionally, infectious disease specialists may work in outpatient clinics or specialty practices, where they see patients for consultations, follow-up visits, and ongoing management of infectious diseases. In these settings, infectious disease specialists evaluate and treat patients with a wide range of infectious conditions, such as HIV/AIDS, tuberculosis, sexually transmitted infections, travel-related infections, and chronic infections requiring long-term antibiotic therapy. They may also provide preventive services, such as immunizations, pre-exposure prophylaxis (PrEP), and counseling on infection prevention and risk reduction behaviors.
Moreover, infectious disease specialists may be involved in public health initiatives, research endeavors, or academic pursuits related to infectious diseases. They may work in public health departments, research institutions, or universities, where they contribute to infectious disease surveillance efforts, outbreak investigations, epidemiological studies, and clinical trials. Infectious disease specialists may also engage in teaching medical students, residents, and fellows in infectious diseases, disseminating knowledge through publications and presentations, and collaborating with colleagues on research projects to advance understanding and treatment of infectious diseases.
Frequently Asked Questions
Doctor Specializations and Degrees
Specializations
The following is a comprehensive list of the various specializations that a doctor can pursue and a brief summary of each specialization:
- Allergist: An allergist specializes in the diagnosis and treatment of allergies, asthma, and related conditions. Allergists have specialized training in the recognition and management of allergic reactions.
- Anesthesiologist: An anesthesiologist keeps a patient comfortable, safe and pain-free during surgery by administering local or general anesthetic.
- Cardiologist: A cardiologist specializes in finding, treating, and preventing diseases that affect the heart, the arteries, and the veins.
- Cardiothoracic Surgeon: A cardiothoracic surgeon specializes in surgical procedures inside the thorax (the chest), which may involve the heart, lungs, esophagus, and other organs in the chest. As well as performing surgery, they also diagnose and treat diseases of these organs.
- Chiropractic Neurologist: A chiropractic neurologist is a specialized type of chiropractor who has undergone additional training in the field of neurology. They diagnose and treat conditions that affect the brain, spinal cord, and other parts of the nervous system.
- Chiropractor: A chiropractor, or doctor of chiropractic medicine, specializes in diagnosing and treating disorders of the musculoskeletal and nervous system, especially in the spine. Treatment is usually physical manipulation of the joints and the spine to bring them back into alignment. A chiropractor does not perform surgery or prescribe medication.
- Colorectal Surgeon: A colorectal surgeon specializes in diseases of the colon, rectum, and anus, as well as the entire gastric tract. These surgeons work closely with urologists, who handle the urogenital tract in males and the urinary tract of women, gynecologists, who deal with specific female issues, and gastroenterologists, who deal with diseases of the gut.
- Doctor: An general overview of what a doctor does and how to become one.
- Dentist: Dentists identify potential oral health issues such as gum disease, as well as examine patients, order medical tests and determine the correct diagnosis and treatment. They also perform oral surgery and remove teeth or address other dental health problems.
- Dermatologist: A dermatologist specializes in the prevention, diagnosis, and treatment of conditions affecting skin, hair, sweat and oil glands, nails, and mucus membranes (inside the mouth, nose, and eyelids) which can include cancer.
- Emergency Medicine Physician: An emergency medicine physician works in emergency departments, hospitals, and urgent care clinics, and is often the first medical professional that patients see when they are in need of urgent medical care.
- Endocrinologist: An endocrinologist specializes in diagnosing conditions and diseases related to the glands and hormones. While primary care doctors know a lot about the human body, for conditions and diseases directly related to glands and hormones they will typically send a patient to an endocrinologist.
- Family Practitioner: A family practitioner specializes in caring for the entire family. Patients can be children, adults, and the elderly, and are treated for a wide array of medical issues.
- Forensic Pathologist: A forensic pathologist investigates the cause of sudden and unexpected deaths, and is able to determine how a person died by performing an autopsy and studying tissue and laboratory results. These doctors are often called upon to provide evidence in court regarding the cause and time of such deaths.
- Gastroenterologist: A gastroenterologist has specific training in diagnosing and treating conditions and diseases of the gastrointestinal (GI) tract. This may include diseases and disorders that affect the the biliary system (liver, pancreas, gallbladder, and bile ducts), as well as the esophagus, stomach, small intestine, and large intestine (colon).
- Geriatrician: A geriatrician specializes in the care of elderly patients, and often works with patients who have multiple chronic conditions, such as hypertension, diabetes, and heart disease, as well as age-related cognitive and functional impairments.
- Gynecologist: A gynecologist specializes in women's reproductive systems. Gynecologists are also sometimes certified as obstetricians, and will monitor the health of the mother and the fetus during a pregnancy.
- Hematologist: A doctor who specializes in the diagnosis and treatment of blood disorders, such as anemia and leukemia.
- Hospitalist: A hospitalist is a physician whose focus is the general medical care of hospitalized patients. Their duties include patient care, teaching, research, and leadership related to hospital medicine.
- Immunologist: An immunologist specializes in managing problems related to the immune system, such as allergies and autoimmune diseases. A smaller number of immunologists are strictly researchers seeking to better understand how the immune system works and to help develop better ways of diagnosing and providing treatment for many immunological conditions.
- Infectious Disease Specialist: A doctor who specializes in the diagnosis and treatment of infectious diseases, such as HIV/AIDS, tuberculosis, and hepatitis.
- Internist: An internist is a 'doctor of internal medicine' who can diagnose, treat, and practice compassionate care for adults across the spectrum, from health to complex illness. They are not to be mistaken with "interns," who are doctors in their first year of residency training.
- Medical Examiner: Medical examiners are responsible for performing autopsies and collecting evidence related to the circumstances of a death, including medical history, physical examination findings, and toxicology tests.
- Naturopathic Physician: A naturopathic physician blends modern scientific medical practice and knowledge with natural and traditional forms of medical treatment. The goal is to treat the underlying causes of disease while stimulating the body's own healing abilities.
- Nephrologist: A doctor who specializes in the diagnosis and treatment of kidney diseases. They treat conditions such as chronic kidney disease, acute kidney injury, kidney stones, hypertension, and electrolyte imbalances.
- Neurologist: A neurologist specializes in treating diseases that affect the human nervous system. It is a very prestigious and difficult medical specialty due to the complexity of the nervous system, which consists of the brain, the spinal cord and the peripheral nerves.
- Neurosurgeon: A neurosurgeon specializes in the diagnosis and surgical treatment of disorders of the central and peripheral nervous system. This includes congenital anomalies, trauma, tumours, vascular disorders, infections of the brain or spine, stroke, or degenerative diseases of the spine.
- Obstetrician: An obstetrician is a medical doctor who specializes in caring for women during pregnancy, childbirth, and the postpartum period.
- Occupational Physician: Occupational medicine is focused on keeping individuals well at work, both mentally and physically. As workplaces become more complex, occupational physicians play an important role in advising people on how their work can affect their health.
- Oncologist: An oncologist specializes in the diagnosis and treatment of cancer. The three primary types of oncologists are: medical oncologists that specialize in the administration of drugs to kill cancer cells; surgical oncologists that perform surgical procedures to identify and remove cancerous tumors; and radiation oncologists that treat cancer with radiation therapy.
- Ophthalmologist: An ophthalmologist is a specialist that deals specifically with the structure, function, diseases, and treatment of the eye. Due to the complexities and the importance of the eye as a special sense that provides vision, the discipline of ophthalmology is dedicated solely to this organ.
- Oral and Maxillofacial Surgeon: An oral and maxillofacial surgeon treats dental and medical problems involving the oral cavity and the maxillofacial area. The maxillofacial area includes the bones of the forehead, face, cheekbones and the soft tissues. Treatment often involves performing surgery and related procedures to treat diseases, defects, or injuries, and to improve function or appearance.
- Orthodontist: An orthodontist specializes in how the jaws and teeth are aligned. They help people whose teeth are misaligned or require some kind of correction – those with an improper bite, or malocclusion.
- Orthopedic Surgeon / Orthopedist: An orthopaedic surgeon (or orthopedist) examines, diagnoses, and treats diseases and injuries of the musculoskeletal system. This system includes the bones, joints, ligaments, muscles, tendons, and nerves.
- Osteopathic Physician: Osteopathic physicians (DOs) are fully licensed medical doctors who diagnose, treat, and help prevent illness and injury, with an added focus on the body’s musculoskeletal system. They combine conventional medical practices with a holistic approach that emphasizes whole-person care and preventive health.
- Otolaryngologist: Otolaryngologists (or ENT physicians) are specialists trained in the diagnosis and treatment of patients with diseases and disorders of the ear, nose, throat (ENT), and related structures of the head and neck. These specialists are trained in both medicine and surgery.
- Pathologist: A pathologist studies the causes, nature, and effects of disease. The field of pathology is broad with concentrations on changes in cells, tissues, and organs that are the result of a disease.
- Pediatrician: A pediatrician specializes in providing medical care to infants, children and teenagers by administering treatments, therapies, medications and vaccinations to treat illness, disorders or injuries.
- Periodontist: A periodontist is a dentist who specializes in oral inflammation, and who knows how to prevent, diagnose, and treat periodontal disease.
- Plastic Surgeon: A plastic surgeon specializes in reshaping healthy body parts for aesthetic reasons, and also in repairing or replacing body parts damaged by accidents, illness or malformation.
- Podiatrist: A podiatrist practices podiatric medicine, which is a branch of science devoted to the diagnosis, treatment and study of medical disorders of the foot, ankle, lower leg and lower back. In the U.S. and Canada, podiatry is practiced as a specialty.
- Prosthodontist: A prosthodontist specializes in restoring the look, function, comfort, and health of a patient's oral cavity with artificial materials. These artificial materials are made up of a wide variety of restorations that include fillings, dentures, veneers, crowns, bridges and oral implants.
- Psychiatrist: Psychiatrists are physicians who evaluate, diagnose and treat patients who are affected by a temporary or chronic mental health problem.
- Pulmonologist: A pulmonologist specializes in the diagnosis and treatment of pulmonary (lung) conditions and diseases of the chest, particularly pneumonia, asthma, tuberculosis, emphysema, and complicated chest infections.
- Radiologist: A radiologist is a specialist in interpreting medical images that may be obtained with x-rays, (CT scans or radiographs), nuclear medicine (involving radioactive substances, magnetism (MRI), or ultrasound.
- Rheumatologist: A doctor who specializes in the diagnosis and treatment of rheumatic diseases, such as rheumatoid arthritis and lupus.
- Sports Medicine Physician: A sports medicine physician specializes in taking care of people who have sports injuries that may be acquired from playing sports, exercising, or from otherwise being physically active.
- Surgeon: A surgeon performs surgery for the purpose of removing diseased tissue or organs, to repair body systems, or to replace diseased organs with transplants.
- Telemedicine Physician: A telemedicine physician provides remote healthcare services to patients using telecommunications technology, facilitating virtual consultations, diagnoses, and treatment recommendations.
- Urologist: A urologist specializes in the treatment of the male and female urinary tract and the male reproductive organs. Urologists can treat the kidneys, urinary bladder, urethra, uterus, and male reproductive organs. There are also specific specialty areas that urologists may choose to focus on, such as pediatric urology, male infertility, and urologic oncology.
- Vascular Medicine Specialist: A vascular medicine specialist specializes in the diagnosis and nonsurgical treatment of conditions affecting the blood vessels. They may work with patients who have conditions such as deep vein thrombosis, peripheral artery disease, or pulmonary embolism.
- Vascular Surgeon: A vascular surgeon specializes in the diagnosis and surgical treatment of conditions affecting the blood vessels, including aneurysms, peripheral artery disease, and varicose veins.
- Veterinary Dentist: A veterinary dentist is a specialized veterinarian who focuses on the diagnosis, treatment, and prevention of dental diseases and conditions in animals. They perform dental procedures such as cleanings, extractions, and oral surgeries to improve the oral health and well-being of pets and other animals.
- Virologist: A virologist is a scientist or medical doctor who studies viruses, develops treatments and vaccines, and works to prevent and control viral diseases.
Related Degrees
- Dentistry
- Medicine
- Naturopathic Medicine
- Osteopathic Medicine
- Podiatric Medicine
- Pre-Dentistry
- Pre-Medicine
- Veterinary Medicine